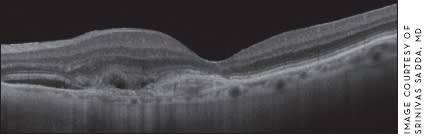

What's Ahead for Optical Coherence Tomography?
Experts weigh in with their opinions on the future of this technology.
DIANE DONOFRIO ANGELUCCI
As baby boomers enter their golden years, many are struggling with age-related macular degeneration and other retinal diseases. Researchers have reported that more than 1.75 million Americans are affected by the disease, and as the population ages, it is estimated this will increase to almost three million by 2020.1
To keep pace with the needs of these patients, and their physicians, researchers continue to refine optical coherence tomography. Since its introduction, OCT has become an indispensable tool in diagnosing retinal disease and assessing its progression. The revolution began with time-domain OCT, which was valuable clinically and used widely. However, the introduction of spectral-domain OCT catapulted retinal assessment forward monumentally, enabling clinicians to more precisely pinpoint abnormalities, track disease progression, and gauge response to treatment.
"When we went from time-domain to spectral-domain OCT, we went from very sparse data, which were those six lines that were barely covering the area we wanted to image, to a dense pattern of scans that covers most of the area that we want to image," says Alexander Walsh, MD, assistant professor of ophthalmology at the University of Southern California and a member of the retina service at Doheny Eye Institute in Los Angeles.
"In the past, with the slow speed of the time-domain OCT systems, we really couldn't image large sections of the retina," says Peter Kaiser, MD, professor of ophthalmology at Cleveland Clinic's Lerner College of Medicine. "Now, with spectral-domain OCT, we can actually image much larger sections of the retina with very high speeds, and the benefit of that is that we can do things such as actually visualize the retina in three dimensions, get a true volume analysis and measure drusen volume, atrophy and even photoreceptors."
COMING ATTRACTIONS
Although spectral-domain OCT revolutionized retinal assessment, experts believe their are still gains to be had as hardware and software advance.
"Diseases of the outer retina, particularly ones that affect the photoreceptors, are probably going to be treatable in the next decade," says Jay Duker, MD, director of the New England Eye Center in Boston. "We're going to need quantitative assessment of the health and function of the outer retina in order to follow patients on such treatments."
Dr. Kaiser believes future refinements may be helpful in assessing dry macular degeneration. "There are a lot of dry macular degeneration products that are being tested, and we simply don't know how they affect drusen volume and atrophy areas," he says. "These are all things that can be done with spectral-domain OCT and will only improve with future enhancements in speed and resolution."
One approach to achieve increased speed is sweptsource OCT imaging, which may be commercially available within the next few years. "We have a prototype sweptsource machine that can operate at over 300,000 A-scans per second," Dr. Duker says. "The fastest commercially available machine right now is 52,000 A-scans per second." He explains that this will reveal much more information. "You can do very rapid scanning of the same area, and the only change in that area will be the movement of the blood vessels, so you can measure the velocity of the blood by scanning very rapidly in one area and get the velocity pretty accurately."
Increased scanning speed allows for more averaging, improving the signal-to-noise ratio, and faster image acquisition with less concern about patient movement, says SriniVas Sadda, MD, associate professor of ophthalmology at the Doheny Eye Institute. "Retinal tracking, for example, may not be critical at such high speeds," he says.
Another innovation, Doppler OCT, is now becoming commercially available. "With Doppler OCT, we're able to actually image the flow inside the retinal vessels and hopefully in the future in the choroidal vessels, so we could be able to make a perfusion map of the retina, much like, if you look at Doppler pictures of the heart, you can see which way the flow is going," Dr. Kaiser says. This will allow clinicians to detect perfusion abnormalities.
"Through the combination of Doppler OCT and phase contrast OCT, it may be possible to do OCT angiography to essentially look at vessels and flow dynamics without the use of dyes, which would be pretty exciting," Dr. Sadda says.
ADDITIONAL POTENTIAL
Researchers are also exploring additional potential features, such as adaptive optics, which correct for aberrations in the visual system. "The resolution of the cross-sectional B-scan view, the slice through the eye that we look at, isn't going to improve all that much," Dr. Kaiser says. "The current resolution will improve some, but we are approaching the theoretical limit of OCT technology, and we'll have to add things such as adaptive optics to allow us to look, for instance, at individual photoreceptors and retinal pigment epithelial cells."
If adaptive optics does indeed improve transverse resolution, clinicians may be able to examine certain areas at the cellular level, such as the outer segments of individual photoreceptor cells, Dr. Sadda says. There are also ways of improving the axial resolution with advances in the light sources for OCT, according to Dr. Sadda. "These improvements in resolution will allow us to see more layers and their boundaries, and to better understand the effects of diseases on fine structures such as Bruch's membrane."
The value of longer-wavelength imaging is being examined in device prototypes. "Most OCT systems are centered at 840 nm, and longer wavelengths are centered around 1,050 nm," Dr. Walsh says. "That may penetrate into the choroid better."
"With these longer wavelengths, we'll be able to go deeper into the eye, and that allows us to really start looking at the choroidal vasculature and changes in the choroid, much like we were looking at things in the retina with the current OCTs," Dr. Kaiser says. "With some of these newer OCTs, we can actually start characterizing the choroidal patterns and perfusion."
Researchers are also examining functional OCT, which refers to measuring changes that occur in the retina when light is absorbed by the outer segments of photoreceptors and the visual cascade occurs, Dr. Duker says. "An OCT is performed, light of a certain wavelength is briefly shined in the eye, then another OCT is performed immediately afterwards," he explains. "Changes in the reflectivity of the outer retina can be measured, and those changes represent structural changes that occur in the retina as the visual cascade occurs. Whether or not measurements of these changes will be clinically useful, we don't really know. But the ability for OCT to measure both structure and function simultaneously is exciting"
While researchers continue to assess the value of functional OCT, autofluorescence offers a step toward that goal. "You can combine fundus autofluorescence and OCT images to get a better functional view of the retina," says Dr. Kaiser. "Fundus autofluorescence tells us about the health of the retinal pigment epithelial cells, and you can combine that with an OCT."
In addition, Dr. Sadda explains that experimental new imaging technology called polarization-sensitive OCT is also another area to consider.
"Although one usually just looks at the intensity of the light reflecting back from the retina, you can also look at the polarization state of the reflected light," he says. "Different structures may scramble or alter the polarization state of the reflected light, thus providing additional contrast for identifying structures of interest, such as the retinal pigment epithelium cell layer."

Figure 1. The capabilities of 4-D OCT cone imaging.
SOFTWARE IMPROVEMENTS
Software improvements will be an important part of the next wave of OCT advancement. One enhancement that is eagerly anticipated by clinicians is greater sophistication in dry AMD imaging.
Carl Zeiss Meditec will soon introduce software that helps to quantify the area and volume of drusen, and area of geographic atrophy. The Advanced RPE Analysis module will make use of an algorithm developed by Giovanni Gregori, PhD, at Bascom Palmer to create a map showing elevations in the RPE corresponding to drusen. The Zeiss package will also provide images of geographic atrophy along with an automated segmentation.
"For those who want to follow patients with dry AMD using OCT, the software will allow us to do that very shortly," Dr. Kaiser says. CZM's module is expected to be the first to market, and other companies also have dry AMD packages in development.
"The other [software] area we're starting to look at is Z-plane images or en face imaging, where we're looking from the top down as opposed to from the sides," Dr. Kaiser says. "You see things totally differently when you look from a different angle. Two areas that use en face imaging are visualizing traction from epiretinal phenomena and outer retinal tubulation, which is something that you can really only see in en face imaging. These images require more pixels, so higher acquisition speeds will make those images better."
Dr. Duker believes that software needs to be more quantitatively accurate. "It doesn't always measure what we want it to measure because the software has been designed to only measure certain layers of the retina, and the measurements don't always correlate to disease states," he says. "So for software to improve, it needs to be, first of all, more accurate. It also needs to be able to measure things other than just total retinal thickness, outer retinal thickness, inner retinal thickness or nerve fiber layer."
"We look at retinal thickness or retinal volume, but really I want to know how much subretinal fluid do they have or how much subretinal tissue do they have?" Dr. Walsh says. "We don't have a way to break out those components yet, so even though OCT was revolutionary from the beginning at trying to measure components in an image, we still don't do a very good job of it."
ADDITIONAL OCT APPLICATIONS
Dr. Walsh and his colleagues have invented a binocular instrument implementing OCT for autonomous eye exams; however, a prototype has not yet been built. "I think that's another way OCT can help us take a step forward because it may replace many of the diagnostic instruments in the ophthalmology clinic — from visual field instruments to keratometers and topographers — and a lot of things our technicians do could potentially be done automatically with an instrument like this." He likened the device to a cell phone, which would be inexpensive to produce and run a number of software packages. Researchers are raising funds to produce the device and hope to see it available within the next few years.
"We certainly need it now, and the way our health care system is going, we need to contain costs and provide better care more efficiently because there are more people to take care of," he says. He adds that such a capability will be even more important in the developing world.
Figure 2. Spectral domain OCT image of an eye with a choroidal neo vascular lesion and a thin choroid.
CONSIDERING OPTIONS
Although researchers are studying a number of intriguing ideas, some may never be available commercially. Current spectral-domain OCT will nevertheless continue to be a vital assessment tool. "People always ask me: is it worth going from time domain to spectral domain?" Dr. Walsh says. "Unfortunately, I still find people that think timedomain OCT is good enough."
Proper perspective is needed when considering technological development trends. "I don't want people to be scared away from adopting spectral-domain OCT by the fact that there might be something new coming down the pike," Dr. Walsh says. "The benefits of spectral-domain OCT are tremendous, and the incremental benefits we're going to get from some of these OCT advances in the next couple of years are not going to make or break clinical practice. I do hope that clinical OCT looks different in five or, at the very latest, 10 years. For the time being, spectraldomain OCT gives most of the information that these newer systems are going to give and is far better information than what we could get from time domain." RP
REFERENCES
1. Friedman DS, O'Colmain BJ, Mu�oz B, et al. Prevalence of age-related macular degeneration in the United States. Arch Ophthalmol. 2004;122:564-572.
Editor's note: Dr. Duker has received research support from Carl Zeiss Meditec, Optovue and Topcon. Dr. Kaiser is a consultant for Heidelberg and Carl Zeiss Meditec and has received honoraria from Topcon. Dr. Sadda shares royalties from intellectual property licensed by the Doheny Eye Institute to Topcon. He also serves on the scientific advisory board for Heidelberg and has received or will receive research support from Carl Zeiss Meditec, Optovue and Optos. Dr. Walsh has been a consultant to Heidelberg and Topcon.








